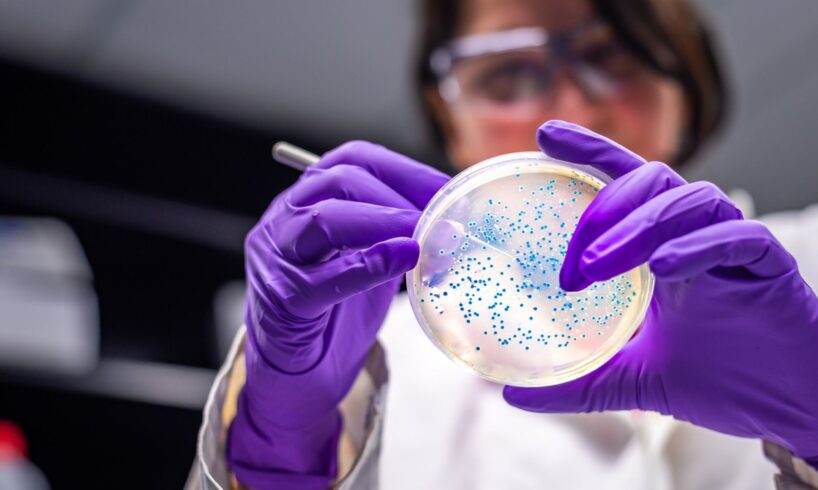

Infections from a strain of E.coli that causes stomach issues rose by more than 25% last year – with toddlers most commonly affected, figures show.
The UK Health Security Agency has said the rise was partly down to a single outbreak linked to contaminated salad leaves, but also warned cases have been gradually increasing since 2022.
The UKHSA and the Food Standards Agency are now urging people to take steps to prevent food poisoning.
There were 2,544 cases of infection with shiga toxin-producing E.coli (STEC) in 2024 – a 26% rise on 2023.
E.coli is a diverse group of bacteria and is normally harmless, living in the intestines of humans and animals.
However, some strains, such as STEC, produce toxins that can cause gastroenteritis – with symptoms ranging from mild to bloody diarrhoea, stomach cramps, vomiting and dehydration.
Image:
iStock file pic
STEC is often transmitted by eating contaminated food but can also be spread by close contact with an infected person, as well as direct contact with an infected animal or where it lives.
Symptoms can last up to two weeks in uncomplicated cases, although some patients, mainly children, may develop haemolytic uraemic syndrome (HUS), which is a serious life-threatening condition resulting in kidney failure.
A small proportion of adults may develop a similar condition called thrombotic thrombocytopenic purpura (TTP).
In 2024, UKHSA and partner agencies investigated five STEC outbreaks involving 467 cases, with 348 in England.
The sources for three of these outbreaks were contaminated beef, fresh fruit and salad leaves.
The largest outbreak was linked to contaminated salad leaves which resulted in 293 cases, including 196 cases in England.
Of the 293 cases, 126 cases needed hospital care, 11 developed complications of HUS, and two died.
Image:
iStock file pic
As a result, a number of food manufacturers recalled sandwiches, wraps and salads sold by major retailers.
According to the UKHSA data, the highest incidence of STEC last year was among children aged one to four, with 357 cases of infection.
Health chiefs said that could be down to a lower immunity or poorer hygiene among children, as well as exposure to risk factors such as contact with farm animals.
Read more from Sky News:
Report to examine death of boy sent home from hospital
Airlines furious after technical glitch cancels flights
Follow Sky News on WhatsApp
Keep up with all the latest news from the UK and around the world by following Sky News
Tap here
Dr Gauri Godbole, the UKHSA’s deputy director of gastrointestinal infections and food safety, said: “While this rise is partly due to one foodborne outbreak, we have been seeing STEC cases gradually increase since 2022 and therefore it’s important for people to take steps to prevent infection.
“If you have any STEC symptoms, like mild to bloody diarrhoea, stomach cramps, vomiting and dehydration, wash your hands with soap and warm water and use bleach-based products to clean surfaces.
“Don’t prepare food for others if you have symptoms, or for 48 hours after symptoms stop.”
Dr Godbole added: “It is important for parents to make sure that young children wash their hands with soap and hot water and dry them thoroughly before eating where possible, especially after playing outdoors and visiting pet farms.
“If you are travelling abroad, it’s important to remember routine hygiene practises to reduce your chances of becoming unwell.
“Rarely, STEC can progress to cause kidney failure and life-threatening illness, particularly in young children and elderly.
“Please consult your GP or healthcare professional if you have blood in your stools or severe dehydration and continue to hydrate yourself.”
Natasha Smith, director of food policy at the Food Standards Agency, urged people to take steps to avoid infection.
“When preparing food at home, people can reduce their risk of food poisoning by following good hygiene practices and by following advice on the 4Cs of food hygiene: chilling, cleaning, cooking and avoiding cross-contamination,” she said.






